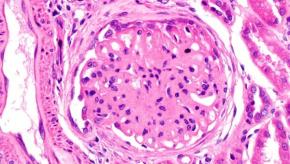
lupus,nephritis,GN

Articles By Md Yuzaiful Md Yusof, MRCP(UK), PhD
ICYMI: SLE: advances to achieve deep B-cell depletion
The race is on for the first chimeric antigen receptor (CAR)-based therapy to be approved for the treatment of systemic lupus erythematosus. Its main principle is to induce deep B-cell depletion, with the hope to reset the B-cell aberrant immunity for a sustained clinical remission. At EULAR 2025 in Barcelona, several advances of CAR-based therapies will be presented.
Read Article
Promising role of Fc neonatal receptor blockade in autoimmune rheumatic diseases
During EULAR 2024, we learned about a novel mechanism of action therapy, nipocalimab in Sjogren’s disease (SjD). This is an anti-neonatal Fc receptor (FcRn) mAb that reduces circulating IgG, including autoantibodies, by selectively blocking the interaction of IgG with FcRn. A year on at EULAR 2025, data from Phase 2 RCT of efgartigimod, an FcRn-inhibitor were presented in autoantibodies positive, moderate to severe active SjD. In addition to SjD, data from Phase 2 RCT of efgartigimod in inflammatory myopathies was presented.
Read Article
Add-on certolizumab in pregnant women with APS
Women with antiphospholipid syndrome and lupus anti-coagulant are at high risk of developing adverse pregnancy outcomes (APO). Usual care includes low molecular weight heparin (LMWH) and low dose aspirin (LDA). Despite these therapies, APO have been reported up to 40%.
Read Article
2025 update of EULAR recommendations on lupus nephritis
At the 2025 EULAR congress in Barcelona, Prof Dimitrios Boumpas presented a summary of the updated EULAR recommendations on the management of lupus nephritis (LN). The most significant change in the treatment paradigm of LN is that the historic standard of care (SOC) (i.e.
Read ArticleSLE Preview: advances to achieve deep B-cell depletion
The race is on for the first chimeric antigen receptor (CAR)-based therapy to be approved for the treatment of systemic lupus erythematosus. Its main principle is to induce deep B-cell depletion, with the hope to reset the B-cell aberrant immunity for a sustained clinical remission. At EULAR 2025 in Barcelona, several advances of CAR-based therapies will be presented.
Read Article
Update on Sjogren's disease trials
With better endpoint and patient selection strategy over the last 4 years, many new therapies have met their endpoints/shown promising signal in the Phase 2 randomised controlled trials in Sjogren's disease (iscalimab, ianalumab, dazodalibep, and sequential therapy belimumab + rituximab). Since many previous studies have shown the discordance between physician assessment and patient’s symptom burden, there is a glimmer of hope with the efficacy signals demonstrated by both iscalimab and dazodalibep in two patient cohorts; a) cohort 1 = high disease activity with variable symptom burden and b) cohort 2 = high symptom burden but low disease activity. EULAR 2024 offered additional updates.
Read Article
Update on low-dose glucocorticoids in SLE
Glucocorticoids (GC) have been the mainstay of treatment in SLE for nearly three quarters of a century. GC induce a range of anti-inflammatory effects, quickly relieve some symptoms and lower mortality in some life-threatening flares. However, they also have multiple side effects that limit the duration of treatment, as well as the dose used. Accordingly, the 2023 EULAR recommendations for SLE set a target dose of ≤5mg/day. Is low dose GC an achievable target?
Read Article
Impact of regulatory warning on JAK inhibitors
The development of JAK inhibitors represents an advance for the treatment of inflammatory rheumatic diseases. However, the enthusiasm in using this target has waned since the publication of the ORAL surveillance clinical trial in 2022. Subsequently, both the FDA and EMA issued a warning on using JAKi in patients with certain risk factors, e.g., ≥65 years, at increased risk of MACE, current smoker or past smoker and at increased risk of cancer, should other alternative treatment be available. So, how has this warning impacted on JAKi development and use?
Read Article
SLE Preview: abolishing refractory with CAR-T and better B-cell therapies
Inhibition of B cell activating factor (BAFF) and B cell depletion are the two most evaluated strategies over the last 15 years in the field of SLE therapeutics, with licensing of belimumab and off-label use of rituximab.
Read Article
ICYMI: Glucocorticoids-free zone in SLE?
For over 70 years, glucocorticoids, (GC) have been a part of standard therapy in SLE. They are classically used to not only induce remission or treat an acute flare, but also as maintenance therapy. They are a valuable 'friend' if used wisely, and can become a 'foe' if used excessively.
Read Article



